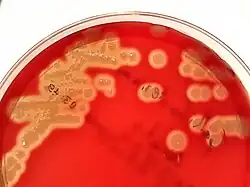

Kultura mikroorganizmów
Kultura mikroorganizmów, hodowla mikroorganizmów – rodzaj hodowli komórkowej, polegającej na utrzymywaniu przy życiu i namnażaniu mikroorganizmów (wzrost mikroorganizmów).
Wzrost mikroorganizmów rozumiany jest jako przyrost biomasy mikroorganizmów jednokomórkowych (jak drożdże, bakterie) lub wielokomórkowych (jak strzępki grzybów pleśniowych) w wyniku biosyntezy substancji komórkowych (np. białek, węglowodanów, kwasów nukleinowych). Wzrost mikroorganizmów można również rozumieć jako przyrost biomasy związany z rozwojem populacji, tzn. zwiększenie zbioru organizmów danego szczepu w danym środowisku[1].
Kultury mikroorganizmów są szeroko stosowane w biotechnologii[2], wykorzystuje się je m.in. do pozyskania ich metabolitów pierwotnych i wtórnych, w celu biotransformacji, bioremediacji oraz w biologii molekularnej[3]. Techniki kultury mikroorganizmów pozwalają na wyizolowanie i identyfikację mikroorganizmów w celach badawczych i diagnostycznych[4].
Metabolizm mikroorganizmów
Mikroorganizmy pod względem strategii metabolicznej można podzielić:
- ze względu na źródło węgla:
- autotrofy – pozyskują węgiel przez asymilację CO
2; - heterotrofy – pozyskują węgiel ze związków organicznych[1];
- autotrofy – pozyskują węgiel przez asymilację CO
- ze względu na sposób odżywiania:
- prototrofy – z podstawowych składników pokarmowych potrafią zsyntetyzować dla siebie czynniki wzrostowe takie jak aminokwasy, zasady purynowe i pirymidynowe oraz witaminy;
- auksotrofy – mikroorganizmy uzależnione od obecności powyższych dodatkowych substancji odżywczych w pożywce[5];
- ze względu na źródło energii:
- fototrofy – pozyskują energię z promieniowania słonecznego;
- chemotrofy – pozyskują energię z utleniania organicznych lub nieorganicznych związków chemicznych;
- ze względu na źródło elektronów:
- litotrofy – źródłem elektronów są związki nieorganiczne, np. H
2, NH
3, H
2S; - organotrofy – źródłem elektronów są związki organiczne[1];
- litotrofy – źródłem elektronów są związki nieorganiczne, np. H
- ze względu na preferowaną temperaturę:
- psychrofile – osiągające optymalne warunki wzrostu w temperaturze w zakresie od 0 do 20 °C[6];
- mezofile – maksymalna szybkość ich wzrostu ma miejsce w zakresie temperatur 20–42 °C[5];
- termofile – rosną najlepiej w temperaturach 40–70 °C, a termofile ekstremalne nawet w wyższych, dochodzących do 105 °C[5].
Podłoża mikrobiologiczne
Podłoża mikrobiologiczne stosuje się do izolacji, różnicowania, identyfikacji, namnażania i badania mikroorganizmów, a także do pozyskiwania określonych produktów ich metabolizmu. Stanowią sztuczne środowisko dla ich wzrostu[7].
Pożywki, na których hodowane są drobnoustroje, można podzielić na płynne i stałe[8]. Hodowle płynne można prowadzić w probówkach, kolbach[9], butlach lub bioreaktorach. Dla równomiernego rozprowadzenia substancji odżywczych i populacji mikroorganizmów może być konieczne stosowanie mieszania, a dla ułatwionej wymiany gazowej – napowietrzania. W hodowli na niewielką skalę (w kolbkach) wykorzystuje się w tym celu wytrząsarki; w hodowli na dużą skalę (w biofermentorach) – mieszadła mechaniczne. Ze względu na występowanie wielu związków odżywczych w pożywce oraz możliwość pozakomórkowego wydzielania różnych związków przez drobnoustroje wytwarzać może się nadmierna piana. Aby temu zapobiec, stosuje się środki antypienne[10]. Hodowle na podłożach stałych prowadzi się na szalkach Petriego, skosach, słupkach[9].
Agar to uniwersalna substancja zestalająca pożywki, nieulegająca rozkładowi przez większość mikroorganizmów. Pożywki stałe zawierają 1,5–2% agaru, a półpłynne – 0,1–0,7%. Inną substancją zestalającą pożywki jest żelatyna. Tworzony przez nią żel upłynnia się jednak w temperaturze 22–25 °C, dlatego ma ograniczone zastosowanie w hodowli bakterii[7].
Pożywki płynne służą przede wszystkim do namnażania drobnoustrojów, a także do przeprowadzania testów biochemicznych; półpłynne – do badania cech takich jak ruch, sprzyjają wzrostowi anaerobicznemu; stałe wykorzystuje się do uzyskania wzrostu powierzchniowego w celu obserwacji wyglądu, specyficznych reakcji biochemicznych, izolacji czystych kultur, przechowywania mikroorganizmów, różnicowania drobnoustrojów, a także namnażania[11][12].
Pożywki stosowane w kulturach mikroorganizmów powinny wykazywać następujące cechy:
- muszą zawierać przyswajalne dla mikroorganizmów źródła pierwiastków biogennych, energii i soli mineralnych;
- powinny wykazywać optymalne pH, potencjał oksydoredukcyjny i odpowiedni poziom ciśnienia osmotycznego dla danego mikroorganizmu;
- muszą być jałowe[7].
Podłoża ze względu na zawartość składników odżywczych można podzielić na:
- minimalne – zawierają tylko składniki pokarmowe niezbędne do podtrzymania wzrostu mikroorganizmów;
- pełne – zawierają wszystkie związki odżywcze niezbędne dla dobrego wzrostu, np. bulion odżywczy do hodowli bakterii, brzeczka do hodowli drożdży;
- wzbogacone – sporządzane dla mikroorganizmów, które słabo rosną in vitro, wymagają dodatkowych substancji odżywczych jak np. krew, surowica, wyciąg wątrobowy, mleko, żółtka jaj[7].
Autotrofy hoduje się zwykle na podłożach minimalnych, bez związków organicznych lub z dodatkiem prostych związków. W przypadku heterotrofów stosuje się często podłoża bogate w substancje organiczne[7].
Źródłem azotu są zwykle aminokwasy i peptydy. Wiele jednak mikroorganizmów, zwłaszcza te żyjące w warunkach naturalnych, wykazuje zdolność wykorzystywania azotu z soli amonowych, azotanów, azotynów, a nawet azotu atmosferycznego. Źródłem siarki są zwykle aminokwasy siarkowe, siarczyny, siarczany, siarkowodór, a rzadziej siarka elementarna. Poza tym drobnoustroje wymagają soli mineralnych, które utrzymują odpowiednie ciśnienie osmotyczne i pH, pełnią ważną rolę w metabolizmie lub są składnikami związków w komórkach[7].
Do przygotowania podłoży do hodowli heterotrofów wykorzystuje się najczęściej wyciągi z tkanek zwierzęcych, np. bulion (wyciąg mięsny). Nieliczne heterotrofy są prototrofami zdolnymi do wzrostu na podłożu zawierającym jedynie prosty związek organiczny (jak glukoza) i sole mineralne[7].
Podłoża ze względu na zastosowanie można podzielić na:
- namnażające – bogate, do pozyskiwania dużej ilości biomasy;
- wybiórczo-namnażające (selektywne) – mające w składzie substancje umożliwiające wzrost określonych mikroorganizmów i hamujące wzrost innych;
- różnicujące (izolacyjne) – mające w składzie indykator pozwalający na odróżnienie określonych grup mikroorganizmów;
- wybiórczo-różnicujące – łączące właściwości podłoży selektywnych i różnicujących;
- transportowe – minimalne, pozwalające na utrzymanie żywotności mikroorganizmów podczas transportu;
- transportowo-wzrostowe – pozwalają na namnażanie drobnoustrojów w trakcie przechowywania, transportu i inkubacji[13].
Zasady hodowli mikroorganizmów
Ogólne zasady hodowli mikroorganizmów
Przenoszenie drobnoustrojów ze środowiska naturalnego na pożywkę lub z pożywki na pożywkę nazywa się posiewem. Najważniejszym jego aspektem jest niedopuszczenie do zakażenia, w związku z czym muszą być zachowane warunki sterylne[8].
Szybkość wzrostu mikroorganizmów zależy od:
- rodzaju i szczepu drobnoustrojów;
- składu pożywki (rodzaj i ilość składników odżywczych, ilość szkodliwych metabolitów);
- fizycznych i chemicznych warunków wzrostu (temperatura, pH, aktywność wody, potencjał redoks)[1].
W przypadku swobodnego dostępu do składników odżywczych, optymalnych warunków otoczenia, braku szkodliwego działania produktów przemiany materii, wzrost mikroorganizmów odbywa się w sposób nieograniczony[1].
| czynnik | bakterie | grzyby strzępkowe | drożdże |
|---|---|---|---|
| wymagania tlenowe | tlenowe lub beztlenowe | tlenowe z pewnymi wyjątkami[15] | względnie beztlenowe |
| wymagania temperaturowe | 30 °C lub 37 °C dla chorobotwórczych dla człowieka | 20–25 °C | 20–25 °C |
| optymalna wartość pH | około 7,4 | około 5,6 | około 5,6 |
| wpływ światła | może hamować wzrost lub je zabijać | brak wpływu | brak wpływu |
| wpływ ciśnienia osmotycznego | w silnie hipertonicznych roztworach ulegają plazmolizie; w hipotonicznych pęcznieją i mogą pękać | są odporne na wysokie ciśnienie osmotyczne | są odporne na wysokie ciśnienie osmotyczne |
| przykładowa pożywka | agar tryptonowo-sojowy (TSA), bulion tryptonowo-sojowy (TSB) | pożywka Sabourauda, podłoże Czapka-Doxa[16] | YPD, brzeczka słodowa[17] |
Sterylizacja
Sterylizacja (wyjaławianie) polega na usunięciu wszystkich, wegetatywnych i przetrwalnych form mikroorganizmów. W hodowli mikroorganizmów sterylizuje się m.in. szkło laboratoryjne, instrumenty, pożywki, zużyte hodowle[18].
Można wyróżnić metody:
- fizyczne – sterylizacja termiczna sucha, sterylizacja termiczna cieplna (z wykorzystaniem pary wodnej), użycie promieni ultrafioletowych, jonizujących, ultradźwięków;
- mechaniczne – filtracja;
- chemiczne[18].
W laboratorium mikrobiologicznym najczęściej używa się metod sterylizacji termicznej[19]. W metodach suchych stosuje się wyżarzanie (eza i inne drobne metalowe narzędzia), opalanie w płomieniu palnika (brzegi probówek, kolb po wyjęciu korka i przed zakorkowaniem, głaszczki szklane po uprzednim zanurzeniu w alkoholu), sterylizacja gorącym powietrzem polegająca na działaniu temperaturą np. 140 °C przez 2,5 h w suszarkach elektrycznych (szalki Petriego, pipety szklane[18], a także inny sprzęt laboratoryjny ze szkła lub metalu[19]).
Sterylizację w gorącej nasyconej parze wodnej przeprowadza się w autoklawach, pod zwiększonym ciśnieniem[19] (stosowane do pożywek, szkła i narzędzi laboratoryjnych)[20]. Inną metodą sterylizacji termicznej mokrej jest tyndalizacja (dla materiałów, które nie nadają się do wyjaławiania w temperaturze przekraczającej 100 °C, np. niektórych pożywek[19]). Może się ona odbywać w aparacie Kocha służącym do sterylizacji w bieżącej parze wodnej[21]. Pożywki wrażliwe na działanie wysokiej temperatury można też wyjaławiać przez filtrowanie przez filtry z porami o średnicy mniejszej od wymiarów bakterii (zwykle 0,2 µm)[19]. Do sterylizacji powietrza i pomieszczeń stosuje się promieniowanie UV[22].
Hodowla grzybów strzępkowych

W odmienny sposób od bakterii i drożdży rosną grzyby strzępkowe. Ich ciało (plecha) stanowi grzybnia zbudowana ze strzępek. Wyróżnia się grzybnię powietrzną (w postaci puchu, pleśni) oraz substratową (wnikającą w podłoże)[23]. W ciekłych pożywkach zazwyczaj tworzy się więcej strzępek substratowych[24]. Poza tym grzyby te wytwarzają zarodniki, które mogą powstawać na drodze płciowej (np. askospory u workowców) lub wegetatywnej (np. konidia, sporangiospory). W podobny sposób jak grzyby strzępkowe rosną również promieniowce[25]. Wzrost grzybów jest wolniejszy niż bakterii, często potrzebują one kilku dni, a nawet tygodni, aby powstały kolonie widoczne gołym okiem[26].
Hodowle okresowe, półokresowe i ciągłe

Faza I – faza adaptacyjna
Faza II – faza wzrostu wykładniczego
Faza III – faza stacjonarna
Faza IV – faza wymierania
W hodowlach okresowych jednorazowo zaszczepiona zostaje określona ilość pożywki. Wzrost drobnoustrojów trwa do wyczerpania się substancji odżywczych lub ich zatrucia przez toksyczne produkty metabolizmu[27]. W takich hodowlach zamkniętych nie dodaje się związków odżywczych w trakcie hodowli ani nie odprowadza namnożonej biomasy i produktów metabolizmu[28]. Wzrost drobnoustrojów obejmuje fazy: adaptacji, wzrostu wykładniczego i fazę stacjonarną. Hodowlę kończy się przed fazą wymierania. Jej zaletami są prostota, łatwość utrzymywania sterylnych warunków i zapobieganie degeneracji mikroorganizmów przez odnawialność inokulum. Wadami są jednak niska produkcyjność i brak możliwości regulacji stężenia limitującego czynnika. Hodowle okresowe stosuje się m.in. do namnażania biomasy mikroorganizmów, pozyskiwania metabolitów pierwotnych (w fazie wzrostu wykładniczego) i wtórnych (w fazie stacjonarnej)[29].
Hodowla półokresowa (okresowa z zasilaniem, ang. fed-batch) to hodowla okresowa z ciągłym dozowaniem pożywki, w której znajduje się czynnik limitujący szybkość wzrostu lub prekursor w biosyntezie produktu[30]. Objętość pożywki jest zmienna. Do zalet metody należy możliwość regulacji stężenia limitującego czynnika, automatyzacji procesów, jednak należy zachowywać jałowe dozowanie pożywki i istnieje ryzyko degeneracji szczepów w wielokrotnych hodowlach[31]. W ten sposób prowadzi się większość przemysłowych procesów fermentacyjnych[30], np. produkcja drożdży piekarniczych, produkcja antybiotyków[31].
W przypadku hodowli ciągłych występuje stały przepływ pożywki przez bioreaktor. Jego natężenie na wlocie do bioreaktora może być regulowane na podstawie gęstości optycznej pożywki (tzw. turbidostat), na podstawie pH – przepływ jest tak sterowany, aby utrzymywać jego stałą wartość (tzw. pH-stat) lub zależeć od stężenia limitującego składnika odżywczego, zwykle źródła węgla lub energii (tzw. chemostat). Natężenie przepływu na wylocie może być regulowane przez różne mechanizmy, np. kontrolę ciężaru, dzięki czemu można utrzymywać stałą ilość pożywki[32]. Procesy te odznaczają się wysoką produktywnością, jednak wadą może być niestabilność genetyczna drobnoustrojów[30].
Hodowle tlenowe i beztlenowe

1. aerob obligatoryjny
2. anaerob obligatoryjny
3. anaerob fakultatywny
4. mikroaerofil
5. anaerob tolerujący tlen
Hodowle mikroorganizmów można również podzielić na tlenowe i beztlenowe.
Tlenowe drobnoustroje (aeroby) wymagają do wzrostu dostępu tlenu. Można je podzielić na hodowle:
- powierzchniowe – na podłożach płynnych (np. produkcja kwasu cytrynowego przez pleśń Aspergillus niger przebiegająca na tacach z pożywką) lub stałych (np. hodowla drobnoustrojów na skosie);
- wgłębne – na podłożach płynnych, gdzie dostęp do tlenu wspomagany jest przez wytrząsanie (np. tworzenie biomasy drożdżowej w warunkach laboratoryjnych) lub przez napowietrzanie (aerację) w bioreaktorach (np. w przemysłowej produkcji drożdży paszowych, antybiotyków)[33].
Techniki te mogą powodować straty materiału biologicznego, konieczność odseparowania biomasy od płynu hodowlanego, a poza tym mogą istnieć ograniczenia w ich zastosowaniu w hodowlach ciągłych. Jeśli celem hodowli nie jest otrzymanie biomasy, lecz procesy przemian za pomocą enzymów zawartych w komórkach, można wiele tych wad uniknąć przez stosowanie unieruchamiania komórek na powierzchni lub w stałym nośniku. Takie hodowle wykorzystywano już w XVII w. w produkcji octu – kolonie Acetobacter na drewnianych wiórach zraszano pożywką, którą stanowił roztwór etanolu[34].
Drobnoustroje beztlenowe wymagają do wzrostu warunków beztlenowych. Wyróżnia się trzy główne metody hodowli mikroorganizmów beztlenowych: fizyczne, chemiczne i biologiczne.
Do fizycznych metod należy hodowla w anaerostatach (słojach próżniowych), w których powietrze zastępowane jest próżnią lub odpowiednim gazem obojętnym (azotem, argonem)[35][36]. Można usunąć powietrze z pożywki płynnej przez zagotowanie jej, szybkie schłodzenie i zalanie podłoża warstwą jałowego, płynnego oleju parafinowego. Stosuje się poza tym hodowle „kłute” w słupkach, pożywkę Wrzoska, łączenie tlenu z wodorem w obecności katalizatora (jak w przypadku zestawów Gas-pak)[36].
Chemiczne metody obejmują stosowanie takich związków w pożywce, które są zdolne do pochłaniania tlenu, np. pirogalol, podsiarczyn sodu oraz obniżające potencjał oksydacyjno-redukcyjny jak kwas askorbinowy, tioglikolan sodu, cysteina[36].
W biologicznej metodzie stosuje się metodę Fortnera polegającą na wysiewaniu na jednym podłożu mikroorganizmu tlenowego (np. Bacillus subtilis) i pożądanego beztlenowego. Płytki szczelnie okleja się np. plasteliną lub parafilmem. Tlenowy mikroorganizm, wyczerpując tlen do swojego wzrostu, stworzy beztlenowe warunki odpowiednie dla pożądanego beztlenowca[36].
Diagnostyka mikrobiologiczna

Diagnostyka mikrobiologiczna ma na celu identyfikację drobnoustrojów. W tym celu należy je zazwyczaj wyosobnić z badanego materiału, uzyskać czyste hodowle, określić cechy morfologiczne (makro- i mikroskopowe), zbadać ich właściwości fizjologiczne i biochemiczne, a następne można stosować np. testy serologiczne (testy aglutynacyjne, techniki immunoenzymatyczne), testy wrażliwości na antybiotyki, typowanie fagowe[37], techniki biologii molekularnej związane z kwasami nukleinowymi (np. amplifikacja DNA, metody hybrydyzacyjne jak hybrydyzacja Southerna, fluorescencyjna hybrydyzacja in situ[38].
Zwraca się uwagę m.in. na[37]:
- budowę komórek drobnoustrojów – wielkość, kształt, układ komórek, występowanie otoczek, rzęsek, przetrwalników;
- wygląd kolonii na płytce – wielkość, kształt, powierzchnię, wzniesienie, brzeg, wzrost powierzchniowy lub wgłębny, przejrzystość, barwę, konsystencję;
- wzrost rysowy na skosie agarowym – typ wzrostu (np. jednolity, paciorkowaty, drzewiasty), wzniesienie, powierzchnia wzrostu, barwa, stan podłoża (np. strawione, wykrystalizowane), zapach
- wzrost na podłożu płynnym – osad na dnie, zmętnienie, wzrost powierzchniowy (np. kożuszek, błonka, obrączka).
W przypadku drożdży istotny jest cykl rozwojowy, zwraca się uwagę m.in. na sposób pączkowania (na jednym końcu komórki, dwóch lub w dowolnym miejscu), obecność i sposób tworzenia askospor[39].
Badanie właściwości biochemicznych

Badanie właściwości biochemicznych przeprowadza się na specjalnych podłożach, często wybiórczo-diagnostycznych zawierających związki hamujące wzrost pewnych mikroorganizmów. Najczęściej w różnicowaniu na podstawie cech biochemicznych wykorzystuje się zdolności rozkładu substratów za pomocą wytwarzanych enzymów, a produkty tych reakcji mogą być wykryte np. za pomocą wskaźników, odczynników[40]. Poza tym wykorzystuje się różnice w mechanizmach oddechowych komórki i umiejętności korzystania ze źródeł podstawowych pierwiastków i energii[41]. Badane są m.in. właściwości glikolityczne (związane z rozkładem węglowodanów), proteolityczne (związane z rozkładem białek), lipolityczne (związane z rozkładem lipidów i kwasów tłuszczowych), utleniająco-redukcyjne. Sprawdzane są one łącznie w tzw. szeregach biochemicznych. Ze względu na dużą różnorodność w tworzeniu enzymów przez drobnoustroje na podstawie cech biochemicznych można rozróżnić rodzaje, gatunki, a nawet szczepy[40].
Przykładowo na podłożu Kliglera bada się zdolność mikroorganizmu do fermentacji laktozy lub glukozy oraz wytwarzania siarkowodoru, a na podłożu Christensena z mocznikiem jako jedynym źródłem azotu bada się zdolność do wytwarzania ureazy. Drobnoustroje wytwarzające żelatynazę rozkładają żelatynę do rozpuszczalnych w wodzie peptydów, doprowadzając do jej upłynnienia (przestaje ona krzepnąć w temperaturze pokojowej). Niektóre mikroby mają zdolność lizy erytrocytów ludzi i zwierząt (hemolizy) przez wytwarzanie hemolizyny. Po wysiewie na podłoże z dodatkiem krwi te, które zdolne są do hemolizy, powodują odbarwienia lub zazielenienia pożywki wokół kolonii[42].
Poza klasycznymi, czasochłonnymi i pracochłonnymi metodami można stosować także nowocześniejsze komercyjne zestawy do przeprowadzania takich testów jak np. test API czy probówki Enterotube[40].
Kinetyka wzrostu mikroorganizmów
Opisy wzrostu mikroorganizmów charakteryzują się uproszczeniami i wyrażają jedynie niektóre istotne zależności i wielkości. Różne są przykładowo sposoby rozmnażania drobnoustrojów – bakterie namnażają się przez podział, mogą wytwarzać formy spoczynkowe (przetrwalniki); drożdże rozmnażają się przez pączkowanie, a cykl rozwojowy grzybów pleśniowych jest jeszcze bardziej złożony: wyróżnia się stadium zarodników, rozwój komórek, grzybni oraz tworzenie zarodników. W modelach kinetyki wzrostu mikroorganizmów procesy życiowe i rozmnażanie zwykle sprowadzane jest do przyrostu masy mikroorganizmów[43].
Opis hodowli wgłębnych
Podstawowym parametrem opisującym szybkość przyrostu biomasy mikroorganizmów jest właściwa szybkość wzrostu[44].
– masa mikroorganizmów [g]
– czas [h]
– właściwa szybkość wzrostu [h–1]
Właściwą szybkość wzrostu można zinterpretować jako ułamek biomasy tworzonej w jednostce czasu. Przykładowo wartość 0,3 h–1 oznacza, że ilość biomasy będzie się zwiększać co godzinę o 30%[45].
W fazie wzrostu wykładniczego, gdy właściwa szybkość wzrostu jest stała, zmiany ilości biomasy w czasie można opisać równaniem[44]:
– masa początkowa mikroorganizmów
W kontekście kultur mikroorganizmów często spotyka się również pojęcie czasu podwajania. Oznacza ono czas, w którym ilość biomasy (tj. masa lub liczba komórek) ulegnie podwojeniu[44]. Jego powiązanie z właściwą szybkością wzrostu jest następujące:
– czas podwajania
Czas podwajania i powiązana właściwa szybkość wzrostu są zależne od warunków hodowli[46], m.in. od składu pożywki, temperatury i pH. Ze względu jednak na ograniczenia tempa reakcji metabolicznych nie da się przyśpieszyć wzrostu mikroorganizmów powyżej pewnego maksymalnego poziomu ()[45]. Jeśli wzrost jest limitowany ilością pojedynczego substratu, to najczęściej do opisania wzrostu wykorzystuje się model Monoda, którego równanie jest analogiczne do równania Michaelisa-Menten opisującego reakcje enzymatyczne[44].
– maksymalna właściwa szybkość wzrostu
– stężenie limitującego substratu [g/l]
– stała nasycenia (stała Monoda) [g/l] – stanowi stężenie S, przy którym szybkość wzrostu osiąga połowę maksymalnej wartości (odpowiednik stałej Michaelisa[47]).
Model Monoda może przyjmować uproszczoną formę w zależności od stężenia substratu. Jeśli stężenie substratu limitującego jest wysokie (S >> Ks), to wzór przyjmuje postać
W przypadku niskiego stężenia substratu (S << Ks) właściwa szybkość wzrostu jest proporcjonalna do stężenia substratu limitującego[46]:
Opis hodowli na podłożach stałych
Do opisu wzrostu mikroorganizmów na podłożach stałych stosuje się powszechnie równanie krzywej logistycznej:
– maksymalna ilość biomasy mikroorganizmów hodowanych na danym podłożu
Po początkowym okresie coraz szybszego wzrostu następuje coraz silniejsze jego hamowanie ze względu na ograniczone możliwości rozwoju (krzywa przyjmuje sigmoidalny kształt). Analogicznie w ekologii opisuje się wzrost logistyczny liczebności populacji[48].
Metody otrzymywania czystych kultur


Wyróżnia się hodowle czyste, złożone z jednego szczepu mikroorganizmów, oraz mieszane, gdzie obecne są mikroorganizmy różnych gatunków. Kultury mieszane występują zwykle w środowisku naturalnym. Aby wyodrębnić drobnoustroje, stosuje się metody otrzymywania czystych kultur[49]. Czyste kultury to kolonie powstałe z pojedynczych komórek drobnoustrojów. Jedynie na takich kulturach można przeprowadzać badania diagnostyczne, fizjologiczne i morfologiczne[50].
Metody bezpośrednie
Mikromanipulatory
Stosowanie mikromanipulatorów polega na pobraniu bezpośrednio pod mikroskopem jednej komórki mikroorganizmu z hodowli mieszanej. Po przeniesieniu jej do jałowej pożywki dzieli się ona, tworząc kolonie złożone z osobników jednego szczepu – hodowla czysta[27][49].
Metoda kropelkowa
Inną metodą bezpośrednią jest tzw. metoda kropelkowa[51] mająca zastosowanie do izolacji mikroorganizmów widocznych pod zwykłym mikroskopem bez stosowania immersji, np. drożdży. Polega ona na rozcieńczaniu małych kropelek zawiesiny drobnoustrojów na szkiełku nakrywkowym w taki sposób, aby w przynajmniej części kropelek znajdowała się tylko jedna komórka. Następnie, przygotowując preparat w postaci tzw. kropli wiszącej (ang. hanging drop slide), oznacza się krople z jedną tylko komórką. Przeprowadza się inkubację pozwalającą na namnożenie się komórek, po której oznaczone krople przenosi się na jałową pożywkę, tworząc hodowlę czystą[49].
Metody pośrednie
Metoda seryjnych rozcieńczeń
Metoda ta polega na wielokrotnym rozcieńczaniu zawiesiny drobnoustrojów w taki sposób, aby w probówce (lub w 1 cm3 ostatniego rozcieńczenia[50]) otrzymać jedną komórkę mikroorganizmu. Jako metoda otrzymywania czystych kultur jest bardzo pracochłonna i nie daje pewności, czy uzyskana hodowla pochodzi z jednej komórki, dlatego właściwie nie ma praktycznego zastosowania[49][51]. Jednak serie rozcieńczeń stosuje się powszechnie w połączeniu z posiewem na płytki[49].
Metody płytkowe
Posiew redukcyjny




Metoda ta polega na pobraniu materiału za pomocą ezy i jego rozprowadzeniu na powierzchni pożywki na szalce Petriego w taki sposób, aby przynajmniej na jej części zostały naniesione pojedyncze komórki, z których wyrosną kolonie. Przeniesienie takiej kolonii na nowe jałowe podłoże zapoczątkowuje rozwój czystej kultury[49].
Posiew powierzchniowy (metoda płytek mazanych)

Metoda ta polega na sporządzeniu kolejnych rozcieńczeń (np. serii dziesięciokrotnych rozcieńczeń) badanego materiału w jałowej wodzie lub płynie fizjologicznym. Z rozcieńczeń pobiera się określoną objętość materiału, przenosi na zestalone podłoże na płytce i rozprowadza głaszczką po jej powierzchni. Po inkubacji na płytkach, na których posiano duże ilości mikroorganizmów z niewielkich rozcieńczeń, obserwuje się ich wzrost w postaci nalotu, natomiast posianie drobnoustrojów z dużych rozcieńczeń pozwala na wzrost w postaci pojedynczych kolonii[51].
Posiew wgłębny (metoda płytek lanych)
Z rozcieńczonego materiału pobiera się określoną objętość, przenosi na sterylną szalkę Petriego i dodaje upłynnioną (ale nie gorącą) pożywkę agarową. Po zestaleniu i inkubacji na płytce wyrastają mikroorganizmy w ilości zależnej od zastosowanego rozcieńczenia[52]. Powstają w ten sposób kolonie powierzchniowe, wgłębne i denne[49].
Metoda płytek odciskowych (replik)
Metoda replik służy od izolowania drobnoustrojów o pożądanych cechach spośród mieszaniny zróżnicowanej wewnętrznie populacji mikroorganizmów (tzw. screening). Przykładowo na jednej płytce rosną kolonie fermentujące i niefermentujące laktozy, oporne i wrażliwe na działanie ampicyliny (antybiotyku), zdolne i niezdolne do wzrostu bez obecności witaminy w podłożu. Aby zlokalizować te o określonych cechach, do płytki przykłada się jałowy stempel pokryty welurem. Stempel ten jest następnie odciskany na powierzchni innych płytek umożliwiających stwierdzenie występowania cechy. W powyższym przykładzie byłyby to płytki z pożywką bez witaminy (wyrosną kolonie zdolne do wzrostu bez niej), z pożywką z ampicyliną (wyrosną kolonie oporne na nią), z pożywką z laktozą i wskaźnikiem (wyrosną kolonie zdolne do rozkładania jej). Zlokalizowanie kolonii o odpowiednich właściwościach i ocena ilościowa możliwa jest po porównaniu odcisków na tych trzech płytkach z płytką macierzystą[53].
Czyste kultury grzybów strzępkowych
W przypadku grzybów czyste kultury otrzymuje się zazwyczaj przez izolację pojedynczych spor lub pobranie końców strzępek (ang. hyphal tip method)[54]. Wielu mikrobiologów uważa jednak za czyste kultury tylko te, które wykiełkowały z pojedynczej spory[55].
Najczęstszym problemem przy izolacji grzybów jest zanieczyszczenie bakteriami i drożdżami. Dlatego też spory rozcieńcza się (co zmniejsza ryzyko zanieczyszczenia przez drożdże) i używa różnych antybiotyków (które redukują zanieczyszczenia bakteryjne)[56]. W celu otrzymania kultur jednozarodnikowych (powstałych z jednego zarodnika) można zastosować rozcieńczenie w jałowej wodzie zarodników czystej kultury[24]. Można tego dokonać np. przez przeniesienie igłą preparacyjną jak najmniejszego fragmentu zarodnikującej grzybni do kropli sterylnej wody na szalce Petriego z pożywką[57], używając dobrej lupy lub mikroskopu stereoskopowego[55]. Gęstość zarodników w rozcieńczeniu można również kontrolować mikroskopowo i dopiero po sprawdzeniu zawiesiny, kilka kropel umieścić na pożywce[24]. Można także dokonać tego za pomocą mikromanipulatora[24][55].
Inną szeroko stosowaną metodą jest pobranie końców strzępek; przydaje się ona zwłaszcza w przypadku niezanieczyszczenia innym grzybem lub gdy grzyb produkuje bardzo niewiele spor. Szybkość wzrostu izolowanego grzyba musi być większa od ewentualnych innych niepożądanych mikroorganizmów[55]. W tym celu można pobrać np. niewielki bloczek agaru z grzybnią powietrzną zawierającą końce strzępek, a następnie odcisnąć, rozsmarować lub po prostu umieścić na nowej pożywce w taki sposób, aby grzyb miał do niej dostęp[58].
Przechowywanie mikroorganizmów
Metody przechowywania
Przechowywanie szczepów mikroorganizmów wymaga zachowania czystości mikrobiologicznej, zapewnienia maksymalnej żywotności komórek oraz stabilności ich cech genetycznych i fizjologicznych[59].
W warunkach laboratoryjnych szczepy można przechowywać w temperaturze pokojowej lub w 4 °C na pożywkach stałych bądź płynnych, stosując okresowe przesiewy na nowe pożywki (pasażowanie). Ten sposób przechowywania niesie jednak ryzyko zmian cech morfologicznych, hodowlanych i biochemicznych mikroorganizmów, a ponadto możliwość zanieczyszczenia i pojawienia się mutacji. Metoda ta jest używana do przechowywania drożdży, które w takich warunkach wykazują stabilność cech do 2 lat. Skosy agarowe mogą być dodatkowo zalewane jałową parafiną, aby odciąć dostęp powietrza i ograniczyć metabolizm[59].
Wiele mikroorganizmów wymaga opracowania indywidualnych metod przechowywania. W celu zachowania pożądanych cech drobnoustrojów preferuje się metody ograniczające konieczność pasażowania i minimalizujące aktywność metaboliczną. Stosuje się zatem suszenie, liofilizację i mrożenie[59].
Suszenie
Suszenie bezpośrednio na podłożu zaleca się przede wszystkim do przechowywania obficie sporujących grzybów strzępkowych i promieniowców. Przechowywać można wysuszone skosy oraz same konidia zebrane z pożywki, a następnie wymieszane z jałowym piaskiem, glebą, żelem krzemionkowym lub węglem aktywnym. W ten sposób można przechowywać kultury grzybowe przez kilka lat[59].
Liofilizacja
Do przechowywania organizmów można stosować proces liofilizacji. Zawiesinę komórek mrozi się w temperaturze –70 °C, a następnie suszy w warunkach próżniowych (następuje wtedy sublimacja wody). Ze względu na dużą śmiertelność u utrwalanych tym sposobem komórek stosuje się zawiesinę komórek z wczesnej fazy stacjonarnej, o dużej gęstości, z dodatkiem czynników ochronnych (np. odtłuszczone mleko, sacharoza)[59].
Mrożenie
Innym sposobem przechowywania kultur, które nie wytwarzają przetrwalników i słabo przeżywają utrwalanie przez liofilizację jest mrożenie w temperaturze od –20 do –70 °C lub w ciekłym azocie (–196 °C). W celu zachowania dużej przeżywalności do zamrożenia przeznacza się komórki z końcowej fazy wzrostu wykładniczego lub z początkowej fazy stacjonarnej. Aby zapobiec niszczeniu struktury komórek, szybkość procesu zamrażania i reaktywacji komórek musi być regulowana. Powolne obniżanie temperatury (1 °C/min) sprzyja powstawaniu dużych kryształków lodu, wzrostowi stężenia elektrolitu i nadmiernej dehydratacji komórek). Ponadto stosuje się czynniki ochronne (krioprotektanty) takie jak glicerol, dimetylosulfotlenek. Następnie roztwory rozlane do ampułek lub fiolek mrozi się[59].
Głęboko zamrożone mikroorganizmy powinny być szybko ożywione, aby uniemożliwić rekrystalizację lodu w komórkach, który mógłby uszkodzić komórki. Po wyjęciu z zamrażarki należy taką kulturę umieścić w łaźni wodnej o temperaturze do 40 °C, a następnie przenieść rozmrożone mikroorganizmy na pożywkę hodowlaną[59].
Kolekcje szczepów
Kolekcje (banki) szczepów to instytucje, które zbierają, utrzymują i wysyłają szczepy mikroorganizmów do laboratoriów mikrobiologicznych do celów edukacyjnych, badawczych, biotechnologicznych etc.[60] Prowadzą badania nad doborem metod przechowalniczych pozwalających uzyskiwać wysoką przeżywalność oraz utrzymanie pożądanych cech. Poza tym do ich zadań należy poszukiwanie nowych szczepów o przydatnych cechach i ich ulepszanie, a także klasyfikacja i identyfikacja mikroorganizmów. W kolekcjach mogą być również deponowane szczepy patentowe. Organizacją zrzeszającą kolekcje jest Światowa Federacja Kolekcji Kultur (WFCC, ang. World Federation of Culture Collection)[59].
Do najbardziej znanych kolekcji szczepów na świecie należy m.in.:
- American Type Culture Collection (ATCC), Manassas, Wirginia;
- ARS Culture Collection (NRRL), Peoria, Illinois;
- Centraalbureau voor Schimmelcultures (CBS) Utrecht, Holandia;
- Deutsche Sammlung von Mikroorganismen und Zellkulturen (DSMZ);
- National Collection of Type Cultures (NCTC), Londyn, Wielka Brytania[59];
- Belgium Coordinated Collection of Microorganism (BCCM), Belgia;
- Collection de L’Institut Pasteur (CIP), Paryż, Francja;
- Japan Collection of Microorganisms (JCM), Tsukuba, Japonia[61].
Do polskich kolekcji zrzeszonych w WFCC należy m.in.:
- Polska Kolekcja Mikroorganizmów (PCM) prowadzona przez Instytut Immunologii i Terapii Doświadczalnej we Wrocławiu;
- Ośrodek Czystych Kultur Drobnoustrojów Przemysłowych (LOCK) prowadzona przez Politechnikę Łódzką, Instytut Technologii Fermentacji i Mikrobiologii;
- Laboratorium Kolekcji Kultur (LCC) prowadzona przez Uniwersytet Warmińsko-Mazurski, Instytut Biotechnologii Żywności w Olsztynie;
- Kolekcja Mikroorganizmów Przemysłowych (IAFB) prowadzona przez Instytut Biotechnologii Przemysłu Rolno-Spożywczego w Warszawie[59].
- Kolekcja Plazmidów i Drobnoustrojów (KPD) na Wydziale Biologii Uniwersytetu Gdańskiego
Szczepionki
Przez izolację i selekcję nowych odmian mikroorganizmów ośrodki badawcze dobierają odpowiednie szczepy do produkcji szczepionek (starterów), które wykorzystywane są w procesach biotechnologicznych. Do ich tworzenia wykorzystuje się czyste kultury i bada ich wzajemne oddziaływanie w hodowlach mieszanych, a także ich działanie antagonistyczne względem niepożądanych drobnoustrojów w procesie technologicznym. Odpowiednio dobrane mikroorganizmy gwarantują wytworzenie typowych cech dla danego produktu, zapewniają wysoką jakość i wydajność[59].
Przy produkcji szczepionek przemysłowych mikroorganizmy namnaża się w optymalnych warunkach, pozyskuje dużą liczbę w pełni aktywnych komórek, dokonuje standaryzacji składu gatunkowego (uzyskanie odpowiednich proporcji gatunków lub szczepów) oraz utrwala poprzez liofilizację lub mrożenie. Ponadto szczepionki bywają przygotowane na skosach lub pożywkach płynnych, zwłaszcza dla przemysłu winiarskiego, gorzelnianego i browarnianego. Pozwala to na ich bezpośrednie namnażanie. W przypadku grzybów mikroskopowych szczepionki mogą mieć formę mieszaniny wysuszonych zarodników w sterylnym piasku, węglu aktywnym, cytrynianie wapnia lub występować jako liofilizaty zarodników lub grzybni[59].
Wizualizacja mikroorganizmów

Mikroorganizmy można wizualizować technikami mikroskopowymi. Tego typu obserwacje wymagają przygotowania preparatu mikroskopowego, który składa się ze szkiełka podstawowego i materiału biologicznego na jego powierzchni. Przygotowanie preparatu obejmuje zwykle oczyszczenie i odtłuszczenie szkiełka, naniesienie zawiesiny mikroorganizmów, wykonanie rozmazu, utrwalenie i barwienie[62].
Utrwalanie może polegać na naniesieniu na wysuszony rozmaz odpowiedniego czynnika chemicznego (np. alkoholu) lub też, metodą termiczną, na 2–3-krotnym przeciągnięciu szkiełka z wysuszonym rozmazem przez płomień palnika. W obserwacjach przyżyciowych etap utrwalania jest pomijany[62].
Do stwierdzania obecności komórek, badania ich morfologii zastosowanie znajduje zwykły mikroskop świetlny, umożliwiając obserwację zazwyczaj po barwieniu preparatu. Odpowiednie barwienie może również zadowalająco wybarwić struktury wewnętrzne. W technice mikroskopowania można wyróżnić obiektywy suche i imersyjne. Obiektywy suche z reguły powiększają słabiej. Między obiektywem a preparatem znajduje się powietrze, które jest ośrodkiem optycznym rzadszym od szkła, dlatego promienie światła załamują się i część nie trafia do obiektywu. Obiektywy imersyjne zwykle silnie powiększają obraz, między obiektywem a preparatem występuje olejek imersyjny. Dobierany jest on w taki sposób, by miał współczynnik załamania światła zbliżony do szkła, dzięki czemu niemal wszystkie promienie, które wychodzą z preparatu, trafiają do obiektywu. Obraz w takim wypadku jest jaśniejszy i zwiększona jest zdolność rozdzielcza mikroskopu. Mając do czynienia z bardzo małymi mikroorganizmami jak bakterie, obiektywy suche stosuje się do odnajdywania odpowiedniego miejsca w preparacie, a obserwacje właściwe wymagają użycia obiektywu imersyjnego[63].
Zastosowanie
Kultury komórkowe są podstawą wszelkich procesów biotechnologicznych[2]. Hodowle mikroorganizmów można wykorzystać m.in. do:
- namnażania komórek w celu produkcji pożywienia (białka z pojedynczych komórek), szczepionek;
- produkcji metabolitów pierwotnych, np. kwasów, alkoholi, enzymów, polisacharydów;
- produkcji metabolitów wtórnych, np. antybiotyków;
- bioremediacji, np. oczyszczanie ścieków, bioługowanie metali;
- biotransformacji związków organicznych;
- różnych procesów w biologii molekularnej, np. produkcji rekombinowanych białek, klonowania genów[3].
Poza tym mikroorganizmy mogą być wykorzystywane np. w nawozach biologicznych, jako bioinsektycydy[64], do tworzenia szczepionek (starterów) przemysłowych[59], jako komórki produkujące ludzką insulinę, interferon i inne białka[64], co możliwe jest dzięki hodowli szczepów udoskonalonych lub genetycznie modyfikowanych[65].
Techniki kultury mikroorganizmów wykorzystuje się w kontroli mikrobiologicznej np. leków, żywności[66]. Dzięki technikom izolacji można uzyskać czyste kultury pozwalające na identyfikację mikroorganizmów i przeprowadzenie badań nad nimi[4]. Wykorzystywane jest to również w medycynie, w diagnostyce chorób. Ponadto można wykonać testy wrażliwości wyizolowanego patogenu na leki przeciwdrobnoustrojowe[67].
Kultury mikroorganizmów mają jednak ograniczone zastosowanie w diagnostyce ze względu na to, że nie wszystkie patogeny udaje się wyhodować in vitro, a poza tym hodowla taka jest czasochłonna (w przypadku większości bakterii – kilka dni). W wielu przypadkach bardziej sprawdza się obserwacja mikroskopowa pobranego materiału do diagnozy (choć czasami wymaga uprzedniego namnożenia patogenu w kulturach), testy immunologiczne (np. testy aglutynacji, immunoprecypitacja, Western blot) oraz analiza kwasów nukleinowych drobnoustrojów (np. PCR, mikromacierze DNA)[67].
Testy immunologiczne można przeprowadzić zwykle szybciej niż trwa wyhodowanie mikroorganizmów w celu wykrycia patogenu. Są bardziej czułe, ale mniej specyficzne, ponieważ u niektórych mikroorganizmów może występować taka sama lub podobna determinanta antygenowa, dlatego częściej używa się ich w przypadku mikroorganizmów trudnych do wyizolowania i hodowli[67].
Przypisy
- 1 2 3 4 5 Goździecki T., Stobińska H., Motyl I.: Wymagania pokarmowe i hodowle mikroorganizmów. W: Żakowska Z., Libudzisz Z., Kowal K.: Mikrobiologia techniczna Tom 1. Warszawa: Wydawnictwo Naukowe PWN, 2007, s. 85–87. ISBN 978-83-01-15221-5.
- 1 2 Nair 2008 ↓, s. 655.
- 1 2 Nair 2008 ↓, s. 676–677.
- 1 2 Steel K. J.. Microbial identification. „Journal of General Microbiology”. 40, s. 143–148, 1965.
- 1 2 3 Schlegel H.G.: Mikrobiologia ogólna. Warszawa: Wydawnictwo Naukowe PWN, 2005, s. 227–232. ISBN 83-01-13999-4.
- ↑ Werel i Wroczyńska-Pałka 2003 ↓, s. 33.
- 1 2 3 4 5 6 7 Różalski 1996 ↓, s. 18–19.
- 1 2 Duszkiewicz-Reinhard, Grzybowski i Sobczak 2003 ↓, s. 38–39.
- 1 2 Gołębiowska i in. 2005 ↓, s. 29.
- ↑ Nair 2008 ↓, s. 660–661.
- ↑ Harley i Prescott 2002 ↓, s. 77.
- ↑ Różalski 1996 ↓, s. 20.
- ↑ Mikołajczyk A., Stefaniuk E., Bosacka K., Hryniewicz W.. Właściwości i zastosowanie podłoży bakteriologicznych. „Postępy Mikrobiologii”. 55 (3), s. 320–329, 2016.
- ↑ Dubey R. C., Maheshwari D. K.: A Textbook of Microbiology. S. Chand & Company, 2013, s. 551. ISBN 81-219-2620-3.
- ↑ Michael K. Theodorou, Sue E. Lowe, Anthony P.J. Trinci: Anaerobic fungi and the rumen ecosystem. W: Carroll G. C., Wicklow D. T.: The Fungal Community: Its Organization and Role in the Ecosystem. New York: Marcel Dekker, 1992, s. 54–55.
- ↑ Basu S., Bose C., Ojha N., Das N., Das J., Pal M., Khurana S.. Evolution of bacterial and fungal growth media. „Bioinformation”. 11 (4), s. 182–184, 2015. DOI: 10.6026/97320630011182.
- ↑ Méndez-Vilas A.: Fuelling the Future: Advances in Science and Technologies for Energy Generation, Transmission and Storage. Boca Raton: BrownWalker Press, 2012, s. 108. ISBN 978-1-61233-558-2.
- 1 2 3 Walczak i in. 2013 ↓, s. 91–92.
- 1 2 3 4 5 Greczek-Stachura M., Bator T.: Ćwiczenia z mikrobiologii ogólnej. Kraków: Wydawnictwo Naukowe Uniwersytetu Pedagogicznego, 2012, s. 7–13. ISBN 978-83-7271-739-9.
- ↑ Werel i Wroczyńska-Pałka 2003 ↓, s. 106.
- ↑ Różalski 1996 ↓, s. 26.
- ↑ Różalski 1996 ↓, s. 31.
- ↑ Morfologia komórki eukariota (pleśnie i drożdże). Wydział Nauki o Żywności Uniwersytetu Warmińsko-Mazurskiego w Olsztynie. [dostęp 2016-11-23]. (pol.).
- 1 2 3 4 Fassatiová O.: Grzyby mikroskopowe w mikrobiologii technicznej. Warszawa: Wydawnictwa Naukowo-Techniczne, 1983, s. 30, 38. ISBN 83-204-0511-4.
- ↑ Różalski 1996 ↓, s. 86.
- ↑ Harley i Prescott 2002 ↓, s. 373–374.
- 1 2 Duszkiewicz-Reinhard, Grzybowski i Sobczak 2003 ↓, s. 42.
- ↑ Różalski 1996 ↓, s. 65.
- ↑ Szewczyk 2003 ↓, s. 61–62.
- 1 2 3 Ratledge i Bjorn 2011 ↓, s. 327.
- 1 2 Szewczyk 2003 ↓, s. 65–66.
- ↑ Ratledge i Bjorn 2011 ↓, s. 324–325.
- ↑ Duszkiewicz-Reinhard, Grzybowski i Sobczak 2003 ↓, s. 44.
- ↑ Szewczyk 2003 ↓, s. 74.
- ↑ Duszkiewicz-Reinhard, Grzybowski i Sobczak 2003 ↓, s. 43.
- 1 2 3 4 Różalski 1996 ↓, s. 70–72.
- 1 2 Różalski 1996 ↓, s. 73–77.
- ↑ Walczak i in. 2013 ↓, s. 150.
- ↑ Różalski 1996 ↓, s. 78–79.
- 1 2 3 Różalski 1996 ↓, s. 163.
- ↑ Werel i Wroczyńska-Pałka 2003 ↓, s. 66.
- ↑ Różalski 1996 ↓, s. 163–179.
- ↑ Bednarski i Fiedurek 2012 ↓, s. 134–135.
- 1 2 3 4 Bednarski i Fiedurek 2012 ↓, s. 136–138.
- 1 2 Hochfeld W. L.: Producing biomolecular substances with fermenters, bioreactors, and biomolecular synthesizers. Taylor & Francis Group, 2006, s. 286–287. ISBN 978-1-4200-2131-8.
- 1 2 Yebo Li, Samir Kumar Khanal: Bioenergy: Principles and Applications. Wiley Blackwell, 2017, s. 94–96. ISBN 978-1-118-56831-6.
- ↑ Ratledge i Bjorn 2011 ↓, s. 321.
- ↑ Bednarski i Fiedurek 2012 ↓, s. 140.
- 1 2 3 4 5 6 7 Różalski 1996 ↓, s. 60–64.
- 1 2 Duszkiewicz-Reinhard, Grzybowski i Sobczak 2003 ↓, s. 40.
- 1 2 3 Duszkiewicz-Reinhard, Grzybowski i Sobczak 2003 ↓, s. 41.
- ↑ Sanders E. R.. Aseptic Laboratory Techniques: Plating Methods. „Journal of Visualized Experiments”. 63, s. 3064, 2012. DOI: 10.3791/3064.
- ↑ Różalski 1996 ↓, s. 64.
- ↑ Singh K. P., Kumar D., Bandyopadhyay P.. A new technique for single spore isolation of two predacious fungi forming constricting ring. „Mycobiology”. 32 (4), s. 197–198, 2004. DOI: 10.4489/MYCO.2004.32.4.197.
- 1 2 3 4 Goh T. K.. Single-spore isolation using a hand-made glass needle. „Fungal Diversity”. 2, s. 47–63, 1999.
- ↑ Choi Y. W., Hyde K. D., Ho W. W. H.. Single spore isolation of fungi. „Fungal Diversity”. 3, s. 29–38, 1999.
- ↑ Błaszkowski J., Adamska I., Czerniawska B., Madej T., Zioło E.: Izolacja bakterii, organizmów grzybopodobnych i grzybów. Przewodnik do zajęć z fitopatologii, 2010. [dostęp 2016-10-16]. (pol.).
- ↑ Chapter 9: Fungi purification, isolation, characterization and preservation. University of Texas Freshman Research Initiative. [dostęp 2016-11-23]. (ang.).
- 1 2 3 4 5 6 7 8 9 10 11 12 13 Stobińska H.: Przechowywanie mikroorganizmów. W: Żakowska Z., Libudzisz Z., Kowal K.: Mikrobiologia techniczna Tom 1. Warszawa: Wydawnictwo Naukowe PWN, 2007, s. 331–338. ISBN 978-83-01-15221-5.
- ↑ Uruburu F.. History and services of culture collections. „International Microbiology”. 6 (2), s. 101–103, 2003. DOI: 10.1007/s10123-003-0115-2.
- ↑ Prakash O., Shouche Y., Jangid K., Kostka J. E.. Microbial cultivation and the role of microbial resource centers in the omics era. „Applied Microbiology and Biotechnology”. 97 (1), s. 51–62, 2013. DOI: 10.1007/s00253-012-4533-y.
- 1 2 Metody badań mikroskopowych. Morfologia komórki prokariota (bakterii). Wydział Nauki o Żywności Uniwersytetu Warmińsko-Mazurskiego w Olsztynie. [dostęp 2016-11-23]. (pol.).
- ↑ Gołębiowska i in. 2005 ↓, s. 9–10.
- 1 2 Khursheed A. M., Claus D.. Bacterial Culture Collections: Their Importance to Biotechnology and Microbiology. „Biotechnology and Genetic Engineering Reviews”. 5 (1), s. 137–138, 1987. DOI: 10.1080/02648725.1987.10647837.
- ↑ Szewczyk 2003 ↓, s. 28–35.
- ↑ Werel i Wroczyńska-Pałka 2003 ↓, s. 115.
- 1 2 3 Miao X., Zhao K., Chen N., Chen Y.: Microbial Culture and Its Clinical Application. W: Li L.: Infectious Microecology. Theory and Applications. Springer, 2014, s. 142–143. DOI: 10.1007/978-3-662-43883-1_6. ISBN 978-3-662-43882-4.
Bibliografia
- Antoni Różalski: Ćwiczenia z mikrobiologii ogólnej. Łódź: Wydawnictwo Uniwersytetu Łódzkiego, 1996. ISBN 83-7016-916-3.
- Wanda Duszkiewicz-Reinhard, Roman Grzybowski, Eugeniusz Sobczak: Teoria i ćwiczenia z mikrobiologii ogólnej i technicznej. Warszawa: Wydawnictwo SGGW, 2003. ISBN 83-7244-431-5.
- Krzysztof W. Szewczyk: Technologia biochemiczna. Warszawa: Oficyna Wydawnicza Politechniki Warszawskiej, 2003. ISBN 83-7207-431-3.
- Włodzimierz Bednarski, Jan Fiedurek: Podstawy biotechnologii przemysłowej. Warszawa: Wydawnictwo WNT, 2012. ISBN 978-83-63623-42-5.
- Colin Ratledge, Kristiansen Bjorn: Podstawy biotechnologii. Warszawa: Wydawnictwo Naukowe PWN, 2011. ISBN 978-83-01-16541-3.
- A. J. Nair: Introduction to Biotechnology and Genetic Enineering. Nowe Delhi: Infinity Science Press, 2008. ISBN 978-1-934015-16-2.
- J. Gołębiowska, H. Kaszubiak, Z. Pędziwilk, W. Kaczmarek: Ćwiczenia z mikrobiologii. Poznań: Wydawnictwo Akademii Rolniczej im. Augusta Cieszkowskiego w Poznaniu, 2005. ISBN 83-7160-391-6.
- W. Werel, M. Wroczyńska-Pałka: Ćwiczenia z mikrobiologii dla studentów Wydziału Farmaceutycznego AMG. Gdańsk: Akademia Medyczna w Gdańsku, 2003. ISBN 83-87047-27-9.
- M. Walczak, A. Burkowska, M. Swiontek-Brzezinska, A. Kalwasińska: Podstawy mikrobiologii w teorii i praktyce. Toruń: Wydawnictwo Naukowe Uniwersytetu Mikołaja Kopernika, 2013. ISBN 978-83-231-3016-1.
- J.P. Harley, L. M. Prescott: Laboratory exercises in microbiology. McGraw-Hill Higher Education, 2002. ISBN 978-0-07-233345-9.